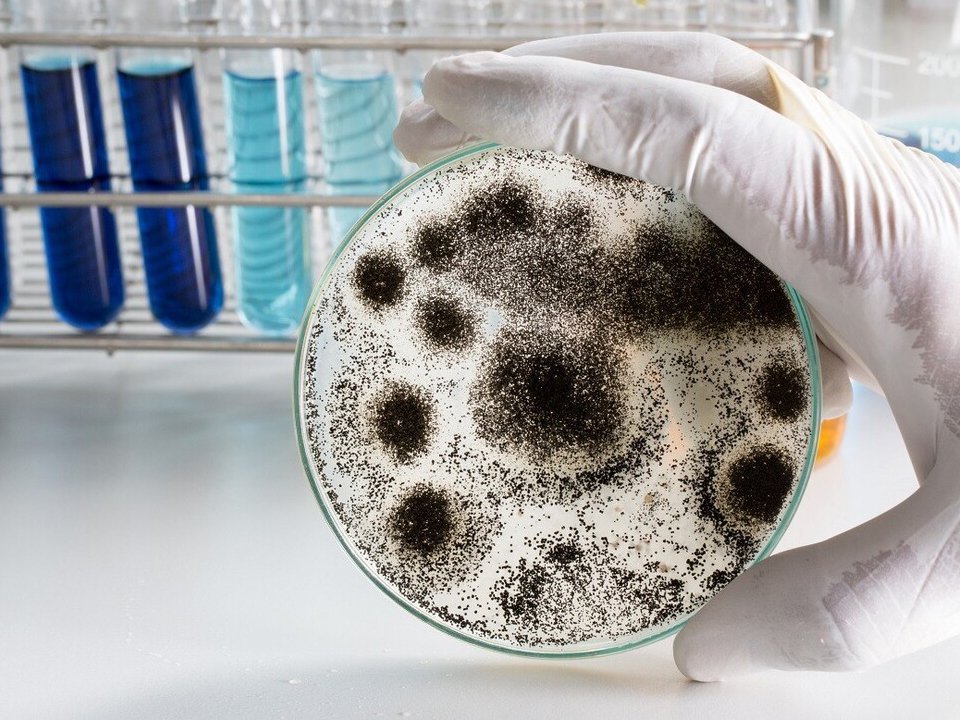

Любая плесень - это грибок, который при определенных условиях отлично приживается и быстро размножается на различных поверхностях…
Читать далееОбработка от плесени в ЗАО
Оставьте заявку на обработку от насекомых
Плесень - неприятность, с которой сталкиваются многие, как в жилых домах, так и на производстве. Грибок плесени разрастается повсеместно, не важно старый это дом, или новостройка, какой климат или погода за окном, зима или лето. Удаление плесени - серьезная задача, которая должна осуществляться профессионалами с применением средств IV класса малоопасных веществ.
Цены на обработку от плесени и грибка
Чтобы рассчитать точную стоимость и заказать услугу, позвоните нашим операторам по номеру телефона или оставьте заявку на.
|
Площадь участка |
Цена базовой обработки |
|
|
1 м2 |
700 р./м2 |
|
|
2-3 м2 |
690 р./м2 |
|
|
3-6 м2 |
680 р./м2 |
|
|
6-10 м2 |
670 р./м2 |
|
|
свыше 10 м2 |
договорная |
|
Площадь участка |
Цена базовой обработки |
|
|
1 м2 |
700 р./м2 |
|
|
2-3 м2 |
690 р./м2 |
|
|
3-6 м2 |
680 р./м2 |
|
|
6-10 м2 |
670 р./м2 |
|
|
свыше 10 м2 |
договорная |
Чем производится обработка?
В зависимости от метража помещения и степени поражения, наши специалисты подбирают специальные препараты для обработки. Используемые химические реагенты совершенно безвредны для людей, домашних питомцев и комнатных растений.
Как долго проводится обработка?
Все зависит от того, помещение какой площади требуется обработать. Небольшое помещение, например, комната дезинфицируется от плесени в течение 30 минут. На большей территории понадобится больше времени.
Опасна ли обработка?
Какой метод обработки бы ни выбрал специалист нашей службы, выполняемые им действия не нанесут вреда обитателям квартиры, дома, работникам производственного помещения, а также домашним питомцам. Используются препараты с 4 классом опасности, разрешённые Роскомнадзором для применения в жилых объектах.
Когда нужно делать обработку?
Если вы заметили плесень, лучше не медлить и не пытаться решить проблему самостоятельно, а вызвать профессиональную помощь. То же самое касается переезда в квартиры старого фонда, жилье на первом или последнем этаже многоквартирного дома, плохо проветриваемых и полуподвальных помещений.
Отзывы клиентов
Контакты службы дезинфекции в Западном административном округе
- Адрес: г. Москва, ЗАО, Рябиновая ул., 26
- Время работы: без выходных с 8:00 до 22:30
Прием заявок круглосуточно - Телефон: +7 (495) 134-16-46
- E-mail: info@dezinfektsiya-spec.ru
Преимущества профессионального удаления плесени

Профессионалы
Наша команда состоит из опытных специалистов, которые обладают глубокими знаниями о различных типах плесени и методиках её уничтожения. Используя передовое оборудование, мы гарантируем высокое качество работ.

Доступные цены
Мы стремимся сделать услуги по уничтожению плесени максимально доступными для широкого круга клиентов без ущерба для качества выполнения работ.

Оперативный выезд
Понимая неотложность проблемы, наш сервис организует быстрый выезд специалистов на объект. Время – ключевой фактор в предотвращении распространения плесени.

Гарантированный результат
Мы не только избавляем ваш дом от плесени, но и принимаем меры для предотвращения её повторного появления, обеспечивая тем самым долгосрочную защиту вашего жилья. Выдаем гарантию на все проделанные работы.
Схема работы
Бесплатная консультация
Заполните форму и получите профессиональную консультацию и расчет обработки прямо сейчас!
Как вызвать специалиста по обработке от плесени
1
Оставьте заявку на сайте или позвоните по нашему номеру +7 (495) 134-16-46
2
Получите бесплатную консультацию и назначьте удобное для Вас время приезда специалиста
3
Приедем в назначенное время
Заключаем договор на оказание услуг
Обработка производится профессионалами, имеющими опыт более 2 лет. Используем исключительно эффективные и безопасные препараты по ГОСТ.

Роспотребнадзором
Используемые препараты и средства
Сертификаты
Для обработки используем только безопасные препараты. На каждый из препаратов есть официальный документ и одобрение Роспотребнадзора

Без неприятного запаха
Используем самые современные препараты и полностью соблюдаем все нормы СанПиН.

Гарантия безопасности
Используем сертифицированные препараты, безопасные для детей и животных.

Результат без дискомфорта
Уже через несколько часов Вы сможете находиться в помещении.

Долгосрочное действие
Остаточный эффект препаратов держится до 7 дней, что позволяет постепенно истребить всю популяцию вредителей.

Эффект уже через 30 минут
Действующие вещества напрямую воздействуют на паразитов и уничтожают их.

Гипоаллергенность
Средства, которые мы используем не вызывают аллергических реакций и раздражения кожи.
Лучшие специалисты

Николай Лежнин
Дезинфектор
Сергей Ильин
Дезинфектор
Виталий Абрамов
ДезинфекторМетоды обработки от плесени
Дезинфекция — это комплекс мероприятий по избавлению от болезнетворных микроорганизмов, включая споры грибка плесени.
При выборе методики борьбы необходим комплексный подход с учетом всех факторов – от климатических условий до материалов конструкции здания. Только так можно достичь эффективного результата и минимизировать вероятность повторного возникновения данной экологически опасной проблемы.
Использование метода горячего тумана — это инновационный и эффективный подход к уничтожению плесени в Москве, который может быть применён как в жилых помещениях, так и на производственных объектах или офисных зданиях.
Метод горячего тумана заключается в распылении специального дезинфицирующего раствора под высокой температурой. В процессе обработки формируется горячий пар или туман, который способен проникать в самые недоступные места, где предпочитает разрастаться плесень.
Разогретый до высоких температур раствор оседает на стенах, потолке и других поверхностях, образуя тонкий слой, который убивает плесень и её споры. При этом также дезинфицируются все поверхности и исчезает неприятный запах.
- Способность к дезинфекции сложных и пористых поверхностей, на которых обычно скапливается плесень. Пар способен проникать в микроскопические трещины и поры материалов, чего невозможно достичь при использовании стандартных способов чистки.
- Высокая эффективность. Горячий туман распределяет антигрибковое средство равномерно по всему объёму помещения, не оставляя необработанными зон.
- Глубокое проникновение. Тепло помогает активным компонентам лучше проникать в материалы и уничтожать плесень даже в глубоких слоях.
- Безопасность. При правильном использовании метод безопасен для людей и животных после проветривания.
- Экономия времени. Обработка от плесени в квартире занимает относительно мало времени по сравнению с другими методами.
- Удаление запахов. Нейтрализует все неприятные запахи, ассоциируемые с плесенью и грибком.
- Продолжительный эффект. Создает на поверхности защитный слой, который предотвращает повторное появление плесени на долгое время.
Метод холодного тумана является одним из самых передовых подходов к уничтожению плесени в Москве.
Метод холодного тумана основан на образовании аэрозольного облака, которое состоит из мельчайших частичек дезинфицирующего раствора. Эти частички способны проникать в самые малодоступные места и уголки квартиры, обеспечивая тем самым всестороннее очищение от плесени и её спор.
- Всесторонняя дезинфекция. Благодаря мельчайшему размеру капель аэрозоля он способен проникать в трещины, поры поверхностей и другие сложнодоступные места.
- Безопасность. Для распыления часто используются дезинфектанты без содержания токсичных веществ, что делает процедуру безопасной для людей и животных.
- Экономия времени. Процесс распыления занимает относительно небольшой промежуток времени по сравнению с классическими методами борьбы с плесенью.
Один из наиболее эффективных способов – орошение поверхностей специализированными антигрибковыми растворами с помощью помповых опрыскивателей.
Орошение представляет собой процесс распыления антимикотических растворов на поверхность, затрагиваемую плесенью. Эти растворы содержат активные химические соединения, которые проникают в структуру грибка и разрушают его клетки изнутри.
Методика орошения может включать предварительную очистку поражённых участков от грубых загрязнений, что повышает эффективность препарата. После обработки необходим контрольный осмотр для оценки результативности проведённой процедуры и при необходимости выполнения повторного орошения.
Преимуществами этого метода являются:
- Глубокое проникновение. Раствор обладает способностью проникать в микроскопические трещины и поры материала, чем обеспечивается уничтожение плесени не только на поверхности, но и вглубь стен.
- Высокая скорость обработки. Большие по площади объекты можно обработать за относительно короткое время.
Механический метод является одним из оптимальных способов борьбы с плесенью в условиях города Москва. Однако следует помнить о том, что после устранения видимых следов плесени целесообразно производить анализ качества воздуха и при необходимости провести дополнительную дезинфекцию помещений для полного удаления возможных оставшихся спор.
Механический метод уничтожения плесени заключается в физическом удалении грибковых колоний с поверхностей. Это либо ручная чистка с использованием различных скребков, шпателей и щеток или применение более сложного оборудования, например, пылесосов с HEPA-фильтрами, которые способны задерживать мельчайшие частицы грибка.
- Безопасность для поверхностей при правильном подходе этот метод не наносит вред материалам стен или предметам интерьера.
- Немедленный результат: после проведения процедуры результат виден невооруженным глазом – все очаги поражения устраняются.
- Подходит для разных поверхностей: может использоваться как на гладких, так и на пористых материалах.
Теплый метод является одним из наилучших решений для борьбы с плесенью в Москве благодаря своей эффективности, экологичности и безопасности как для людей, так и для обрабатываемых поверхностей.
Тепловой метод уничтожения плесени представляет собой процедуру, в ходе которой зараженные поверхности обрабатываются высокими температурами. Принцип действия заключается в том, что плесневые грибы и их споры теряют жизнеспособность при воздействии температуры, превышающей их термический порог. В основном этот метод использует горячий воздух или пар. Один из способов – использование специализированных тепловых пушек или строительных фенов, которые подают горячий воздух на зараженные участки.
Для эффективности процесса необходимо точное соблюдение температурного режима и времени экспозиции. Обычно для уничтожения плесени достаточно подвергнуть ее воздействию температур в диапазоне от 60 до 100 градусов Цельсия на протяжении нескольких минут. Однако точные параметры зависят от типа поверхности и степени заражения.
- Эффективность. Высокие температуры способны проникать в глубокие слои материалов, уничтожая не только видимую плесень, но и её споры, что предотвращает риск повторного заражения.
- Универсальность. Тепловой метод подходит для обработки широкого спектра материалов — от стен и потолков до мебели и текстиля. Однако следует помнить о чувствительности некоторых материалов к высоким температурам.
- Безопасность для материалов. Правильно подобранный температурный режим и время обработки не повредят большинство обрабатываемых поверхностей, что делает метод безопасным для мебели, отделочных материалов и даже электронных устройств после соответствующей подготовки.
Плесень представляет собой грибковые организмы, способные образовывать мицелий и споры. Она может развиваться на различных поверхностях, включая продукты питания, стены, потолки и полы в жилых помещениях.
Причины появления плесени в квартире
Грибок в квартире образуется зачастую из-за:
- избыточной влажности,
- недостаточной вентиляции,
- протечек воды,
- подъема капиллярной влаги через строительные материалы.
- нарушения теплоизоляции,
- конденсация воздуха на холодных поверхностях.
Грибок часто обнаруживается в углах помещений, на стенах за мебелью, на потолках ванной комнаты и кухни, а также рядом с оконными рамами.
Как удалить плесень?
Борьба с плесенью должна начинаться с устранения первопричин её возникновения:
- необходимо обеспечить достаточную циркуляцию воздуха,
- регулировать уровень влажности,
- исправлять все возможные протечки.
После этого можно применять химические или натуральные средства для удаления плесени.
Какой метод выбрать?
Выбор метода зависит от степени поражения и типа поверхности.
Для небольших участков подходят специализированные антигрибковые средства.
В более тяжелых случаях может потребоваться профессиональная санация здания.
К каким заболеваниям приводит плесень
Споры могут вызывать:
- аллергические реакции,
- астма,
- хронический бронхит.
Особенно опасно действие токсигенных видов плесени, вырабатывающих микотоксины.
Способы обработки от плесени и грибка
Средства борьбы делятся на:
- физические (теплообработка, УФ-излучение),
- химические (фунгицидные составы),
- народные (раствор уксуса или перекиси водорода).
Регулярная уборка и проветривание также эффективно предотвращает размножение грибка.
Какие виды плесени бывают в квартирах
В домашних условиях часто можно обнаружить черную плесень (Stachybotrys chartarum), а также белую, зеленую или розовую (Aspergillus spp., Penicillium spp., Fusarium spp.). Каждый вид имеет свои особенности размножения и удаления.

Что делать, если грибок постоянно появляется дома
Плесень - это грибок, который может стать настоящей проблемой для каждого дома. Она не только портит внешний вид помещения, но и может представлять серьезную опасность для здоровья.
Постоянное появление спор свидетельствует о высокой влажности и недостаточной вентиляции в помещении.
Чтобы решить эту проблему, необходимо устранить источник повышенной влажности:
- проверить состояние коммуникаций на предмет течи,
- обеспечить должный отвод воздуха,
- использовать осушители воздуха.
Можно ли справиться самостоятельно?
Справиться самостоятельно действительно можно, однако стоит помнить о потенциальной опасности этого процесса для здоровья.
Перед началом работы необходимо защитить дыхательные пути, глаза и кожу от спор грибка.
Для удаления плесени используют различные антигрибковые средства, которые можно приобрести в хозяйственных магазинах.
Как справиться с плесенью самостоятельно
Для борьбы своими руками следует придерживаться следующих этапов:
- Оценка области поражения: если площадь небольшая, можно приступать к работам самостоятельно.
- Подготовка защитных мер: использование респиратора, перчаток и очков.
- Вентиляция помещения: перед началом работ нужно тщательно проветрить комнату.
- Применение антигрибковых средств: обработка зоны поражения специализированными химикатами.
- Полное высыхание обработанной поверхности после процедуры.
После устранения видимой части следует перейти к профилактическим мерам для предотвращения её повторного появления.
Профессиональная обработка от плесени и грибка
Если же проблема широкомасштабна или регулярно возникает вновь, стоит задуматься о вызове специалистов.
Профессиональная обработка от плесени подразумевает не только использование более мощных антигрибковых препаратов, но и определение точных причин возникновения проблемы и устранение этих факторов. Специалисты оснащены нужным инструментарием для диагностики и эффективного решения задачи по удалению грибка.
В заключение следует подчеркнуть значимость регулярного контроля за уровнем влажности в помещении и своевременного реагирования на признаки появления плесени. Это не только сохранит эстетический вид жилья, но и предотвратит возможные негативные последствия для здоровья обитателей дома.
Плесень представляет собой серьезную угрозу здоровью человека и несет различные негативные последствия для жилых и нежилых помещений. Справиться с этой проблемой можно, применяя последовательный и всесторонний подход, включающий этапы дезинфекции, подготовку к обработке, непосредственное уничтожение плесени, а также последующие действия и профилактику.
Работы наших специалистов
Заполните форму и получите бесплатную консультацию

Этапы дезинфекции помещения от плесени
- Оценка обстановки. Первоначально необходимо оценить степень поражения плесенью и определить, насколько глубоко она проникла в материалы.
- Удаление поражённых материалов. Иногда борьба с плесенью предполагает удаление обоев, отделочных материалов или даже частей стен, если они сильно заражены.
- Очистка поверхностей. Поверхности следует тщательно очистить механическим способом с использованием щеток и специализированных растворов.
- Применение антигрибковых средств. На очищенные поверхности наносят фунгицидные препараты для уничтожения грибка и предотвращения его повторного появления.
- Сушка помещения. После обработки необходимо тщательно проветрить и высушить помещение.
- Финальная обработка и отделка. Завершающий этап - это нанесение защитных составов на поверхности перед окончательной отделкой помещения.
Чем дезинфицируют помещения
Для борьбы с плесенью используются:
- Биоцидные составы, содержащие хлор или другие активные вещества, уничтожающие грибок и споры.
- Фунгицидные краски и грунтовки для предотвращения роста плесени после окончания работ.
- Народные средства, такие как уксус или перекись водорода, могут быть эффективны в случаях лёгкого загрязнения.
Как подготовиться к обработке
Перед началом работы:
- Опустошите помещение от мебели и предметов интерьера.
- Защитите дыхательные пути и кожу - используйте респиратор, перчатки и защитную одежду.
- Обеспечьте доступ свежего воздуха - откройте окна для вентиляции.
Что делать после обработки
После дезинфекции:
- Оставьте помещение закрытым на несколько часов для действия антигрибковых препаратов.
- Тщательно проветрите комнату для удаления остатков химикатов.
- Выполните влажную уборку, чтобы удалить все следы борьбы с плесенью.
Что сделать для лучшего результата
Для достижения наилучшего эффекта:
- Используйте только сертифицированные антигрибковые препараты с подходящей концентрацией активных веществ.
- В случае обширного заражения обратитесь к профессиональным службам по уничтожению плесени.
Профилактика
Чтобы избежать появления плесени в будущем:
- Осуществляйте регулярную вентиляцию помещений.
- Контролируйте уровень влажности - она не должна превышать 40-60%.
- Используйте строительные материалы с антигрибковой добавкой при проведении ремонтных работ.
- Применяйте очистители воздуха и осушители, чтобы поддерживать оптимальный микроклимат.
Таким образом, борьба с плесенью требует комплексного подхода: от первичной оценки до профилактических мер после завершения работы. Своевременная реакция на первые признаки появления плесени будет ключом к сохранению здоровья людей и целостности вашего жилого пространства.
Почему важно проводить удаление плесени в квартире?
Плесневые грибки могут вызывать различные аллергические реакции, проблемы с дыхательными путями и ухудшение общего самочувствия жильцов. Долгосрочное воздействие может привести к развитию хронических заболеваний, особенно у людей с ослабленной иммунной системой. Кроме того, плесень способна разрушать строительные материалы, что может привести к необходимости дорогостоящего ремонта.

Что нужно знать для защиты от плесени
Для защиты от плесени необходимо поддерживать оптимальный микроклимат в помещении: контролировать уровень влажности, обеспечивать хорошую вентиляцию и регулярно проводить уборку. Есть специальные антисептические средства для обработки поверхностей, которые могут предотвратить появление грибка. Немаловажное значение имеет правильная эксплуатация отопительных приборов и систем кондиционирования.
Сколько стоит дезинфекция
Стоимость дезинфекции зависит от множества факторов:
- размера помещения,
- степени заражения плесенью,
- выбранной методики борьбы.
Мы предоставляем бесплатную оценку стоимости работ после выезда специалиста на объект.
Преимущества нашей компании
Наша компания использует передовые технологии для уничтожения плесени и предотвращения её повторного появления.
Мы используем безопасные и эффективные дезинфектанты, а также обладаем всем необходимым оборудованием для работы в труднодоступных местах.
Наш персонал проходит регулярное обучение, что гарантирует высокое качество услуг.
Как заказать выезд сотрудника нашей службы
Для заказа выезда нашего сотрудника достаточно связаться с нами по телефону или через форму на сайте. Менеджер оперативно ответит на все интересующие вопросы и запишет на удобное время для консультации или выполнения работ.
Уничтожение плесени - это комплексное задание, требующее профессионального подхода. Наша компания готова предложить полный спектр услуг по избавлению от данной проблемы быстро и эффективно. Обращайтесь к профессионалам - заботьтесь о своем здоровье и комфорте своего жилья!
Оставьте заявку на сайте, менеджер Вам перезвонит

читайте
Полезные статьи
Плесневые споры постоянно присутствуют в воздухе. Они попадают в помещение через окно или вентиляционную систему, люди приносят…
Читать далееПлесень ― живой микроорганизм из класса грибов, с которым, пожалуй, знакомы многие хозяйки. Столкнуться с плесенью можно…
Читать далее